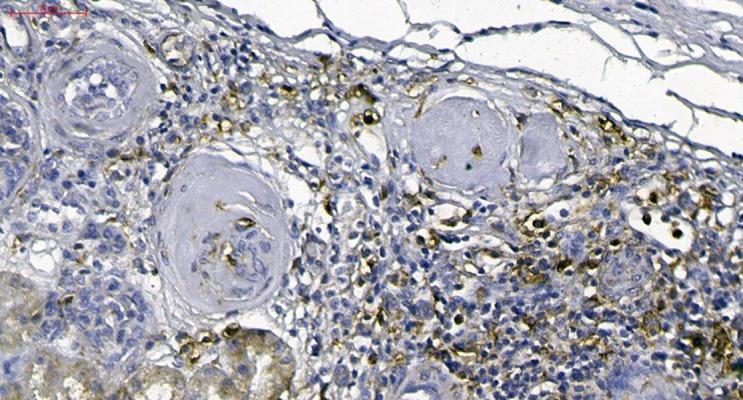
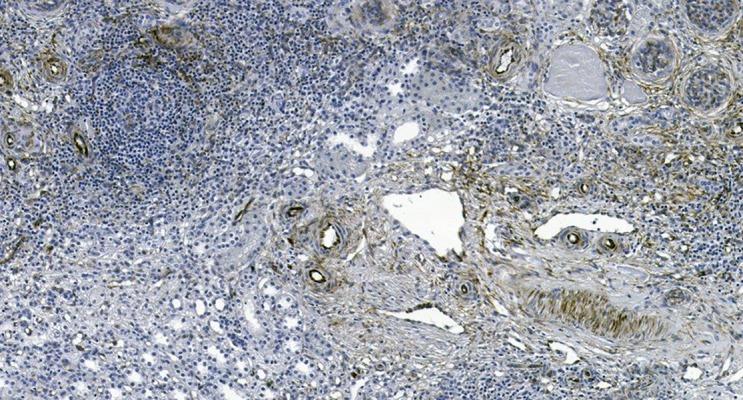

儿童黄色肉芽肿性肾盂肾炎的早期进展可能依赖于波形蛋白的表达。
Early Progression of Xanthogranulomatous Pyelonephritis in Children Might Be Dependent on Vimentin Expression.
作者信息
Ostalska-Nowicka Danuta, Mackowiak-Lewandowicz Katarzyna, Konwerska Aneta, Zachwieja Jacek
机构信息
Department of Pediatric Cardiology, Nephrology and Hypertensiology, Poznań University of Medical Sciences, Poznań, Poland.
Department of Histology and Embryology, Poznań University of Medical Sciences, Poznań, Poland.
出版信息
Am J Case Rep. 2017 Oct 5;18:1066-1072. doi: 10.12659/ajcr.904376.
BACKGROUND Xanthogranulomatous pyelonephritis (XP) is an extremely rare, severe, atypical form of chronic renal parenchymal inflammation accompanied by hydronephrosis and/or urolithiasis. The pathomechanism of XP is not yet fully understood. Microscopically, XP is indicated by the presence of multinucleated giant cells and lipid-laden macrophages, as well as inflammatory infiltration and intensive renal fibrosis. The lipid accumulation in kidney parenchyma may be secondary to the altered flow of low-density lipoprotein (LDL)-derived cholesterol particles inside the affected cells. Physiologically, the process of LDL-derived cholesterol transport from lysosomes to the sites of its esterification is dependent on vimentin, which is a molecule comprising the cytoskeleton in mesenchymal cells. CASE REPORT A 7-year old girl was hospitalized because of the finding of unexplained kidney lesions on an abdominal ultrasound examination (an enlarged and deformed collecting system of the right kidney with hyperechogenic, solid, staghorn lesions in the calyces). Three months earlier, the patient had experienced recurrent urinary tract infection. Based on the subsequent laboratory and imaging diagnostics, the final diagnosis of XP was established and the girl was qualified for right-sided nephrectomy Microscopic examination revealed numerous foci of granuloma formations with no evident exponents of dysplastic or neoplastic abnormalities. Significant CD68-positive cell infiltrations and scattered foam cells arranging the numerous foci of granuloma inflammation were noticed. Renal parenchyma, adjacent to granuloma lesions, presented a vimentin expression. CONCLUSIONS Vimentin expression in XP may confirm a focal character of chronic granuloma formation and may suggest the complexity of XP pathogenesis involving not only macrophage and fibroblast activation but also local lipid deregulation and fibrosis.
背景 黄色肉芽肿性肾盂肾炎(XP)是一种极为罕见、严重的慢性肾实质炎症的非典型形式,伴有肾积水和/或尿路结石。XP的发病机制尚未完全明确。在显微镜下,XP表现为多核巨细胞、充满脂质的巨噬细胞的存在,以及炎症浸润和严重的肾纤维化。肾实质中的脂质蓄积可能继发于受累细胞内低密度脂蛋白(LDL)衍生的胆固醇颗粒流动改变。生理上,LDL衍生的胆固醇从溶酶体转运至其酯化部位的过程依赖于波形蛋白,波形蛋白是一种构成间充质细胞细胞骨架的分子。病例报告 一名7岁女孩因腹部超声检查发现不明原因的肾脏病变(右肾集合系统增大、变形,肾盏内有高回声实性鹿角状病变)而住院。3个月前,该患者曾反复发生尿路感染。基于后续的实验室和影像学诊断,最终确诊为XP,该女孩符合右侧肾切除术条件。显微镜检查显示有大量肉芽肿形成灶,未见发育异常或肿瘤异常的明显表现。注意到显著的CD68阳性细胞浸润以及散在的泡沫细胞排列成众多肉芽肿炎症灶。与肉芽肿病变相邻的肾实质呈现波形蛋白表达。结论 XP中的波形蛋白表达可能证实慢性肉芽肿形成的局灶性特征,并可能提示XP发病机制的复杂性,不仅涉及巨噬细胞和成纤维细胞的激活,还涉及局部脂质失调和纤维化。